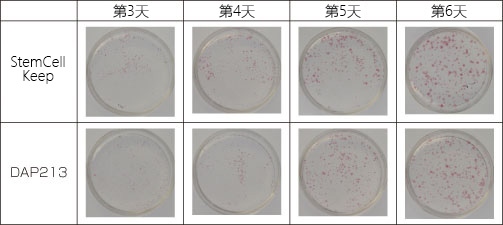
131584069769.jpg

微信扫一扫
关注公众号
StemSure(R) 细胞冻存液
询价
产品分类
- 酶及底物 (520)
- 免疫学 (3087)
- 标准品/对照品 (536)
- 生物制药与疫苗 (604)
- 分离纯化 (37)
- 生化试剂 (28748)
- 分子生物学 (21)
- WAKO (13608)
- Jackson ImmunoResearch (2012)
- Ludger 糖链分析 (87)
- Lumiprobe活性染料 (3)
- abcam (39100)
- Merck-Sigma (44401)
- MP Bio (11006)
- 试剂 (9706)
- 健康原料 (24)
- 新型材料 (345)
- 仪器分析 (1025)
- 合作品牌 (44464)
- Aalto
- AAT Bioquest
- AbD
- Active Motif
- Advanced Targeting Systems
- Ambion
- AnaSpec
- AssayDesign
- Avanti
- Bangs Laboratories
- BioPorto
- BioSource
- bioworld
- cayman
- Chemicon
- Clontech
- CST
- DiFco
- Epigentek
- hampton
- Himedia
- Hyclone
- ldmsapp
- Innova Biosciences
- Invent
- J.T.BAKER
- KPL
- lifespan
- MRC
- Phytotech
- Pierce
- Prozyme
- Qiagen
- R&D
- Roche
- Santa Cruz
- Vector
- Worthington
- 其他分类 (9)
服务保证
西宝风采
公司新闻
适用于灵长类 ES/iPS 细胞的玻璃化冻存液 StemCell Keep
发布时间:2024-03-25 09:24 | 点击次数:469
 适用于灵长类 ES/iPS 细胞的玻璃化冻存液
适用于灵长类 ES/iPS 细胞的玻璃化冻存液
StemCell Keep
StemCell Keep 在保持高玻璃化能的同时,抑制了细胞毒性,是一款适用于灵长类 ES/iPS 细胞的玻璃化冻存液。
※本产品仅供研究使用,研究以外不可使用

◆关于 DAP213 等含有 DMSO 的保存液的问题
DMSO 作为普通细胞冷冻保护成分常被添加到保存液中,但同时也是对人体有害的成分,且极易被皮肤吸收。除具有细胞毒性外,如同下列论文所述,是影响细胞分化的因子之一。因此, DMSO 用于保存并不是十分理想的。现有的玻璃化冻存液 DAP213 中除了高浓度DMSO之外,还被指出含致癌性物质乙酰胺。除此之外,由于其溶质浓度高,还被指出会因为渗透压引起毒性。
另外,使用 DAP213 时,若不能在 10~30 s 内完成保存,那么解冻后的存活率便会大幅下降,而 StemCell Keep 只需在是在约 1 min 内完成保存,且操作难度低,也不需要娴熟的技术。
参考文献
?使用 DMSO 将人骨髓白血病细胞株 HL-60 分化为粒细胞。
Jiang, G., et al., Int. Immunopharmacol., 6 (7), 1204~1213 (2006).
?使用DMSO将小鼠间充质干细胞分化为心肌细胞。
Young, D. A., et al., Biochem. Biophys. Res. Commun., 322 (3), 759~765 (2004).
?使用含有 DMSD 的保存液冻存人ES细胞发现未分化标记 Oct-4 的表达降低。
Katkov, I. I., et al., Cyobiology, 53 (2), 194~205 (2006).
◆玻璃化冻存法是什么
玻璃化冻存法是一种将细胞直接迅速浸没到液氮中防止水结晶,并在非晶质的玻璃状态下进行冷冻的方法。该方法的优点在于水的体积不会膨胀,因此给细胞带来的损害较少。若采用一般冷冻法,灵长类ES/iPS细胞在解冻后的存活率较低,所以我们推荐使用玻璃化冻存法。然而,由于玻璃化需要较高的溶质浓度,存在细胞毒性容易因溶质变高的问题,因此低毒性冻存液的诞生备受期待。
◆关于灵长类ES/iPS细胞保存和玻璃化冻存法
|
灵长类ES/iPS细胞经不起冷冻
|
|
|
|
● 使用一般的10%DMSO保存液缓慢冷冻(置于-80°C)时存活率较低
● 细胞集落冻存后存活率仅为0.1~1%
|
|
建议使用玻璃化冻存法进行保存
|
|
|
|
● 直接浸没于液氮中防止水结晶化,在非晶质的玻璃状态下冷冻的方法
● 将细胞悬浮于玻璃化溶液中,然后立即将整个冻存管浸没到液氮中,使其玻璃化
● 该方法的优点在于水的体积不会膨胀,因此给细胞带来的损害较少
|
|
传统玻璃化冻存法的问题
|
|
|
|
● 玻璃化需要较高的溶质浓度,容易因溶质提高毒性(渗透压)
● 为防止水重结晶,必须迅速解冻
● 需要娴熟的技术
|
|
现有玻璃化冻存法的问题
|
|
|
|
● 为小鼠受精卵玻璃化用而开发,以少量溶液(数μL)即可玻璃化为前提。若用于ES/iPS细胞而增加溶液量(约200 μL的话),则会导致玻璃化状态不稳定,容易重结晶
● 现有的玻璃化冻存液所含的乙酰胺具有致癌性,DMSO还会影响分化(Oct4表达降低),因此不受欢迎
|
|
优化玻璃化溶液
开发StemCell Keep
|
◆特点
● 不含影响分化的DMSO以及动物蛋白成分
● 通过玻璃化法保存可在保持细胞集落状态下进行冻存
● 可在维持干细胞多向分化能的状态下进行(未分化状态)冻存
● 在高安全性新型冷冻保护物质(专利申请中)的高度细胞保护作用以及玻璃状态维持作用下,能够更高效地冻存ES/iPS 细胞集落
● 按照使用方案使用的情况下,可保存100管
● 经无菌测试确认无细菌、真菌、支原体污染
● 本产品可在4°C下长期稳定保存(有效期2年)
※使用台盼蓝处理StemCell Keep保存的细胞时,请务必清洗细胞。
◆案例比较

人iPS细胞冻存
使用现有玻璃化冷冻液(DAP213)以及本产品冻存人iPS细胞一周,图为解冻第二天的细胞集落形成率以及4天后的细胞数量(复苏率)与非冷冻组形成的百分比。结果表明,使用本产品冷冻的组的保护效果明显更好。
◆应用实例1

解冻使用本产品冷冻的人iPS细胞后的未分化标记表达
无论是(A)碱性磷酸酶(AP)、(B)OCT-4、(C)SSEA-4、(D)TRA-1-60都呈阳性,由此可知细胞维持了未分化状态。

解冻使用本产品冷冻的人iPS细胞后的多能性评估
将解冻后的iPS细胞在未经处理的板上培养,制备胚状体后,在普通的培养板上培养一周。检测出了三胚层来源的蛋白。
◆应用实例2
使用本产品保存京都大学来源的人ES细胞(KhES1, KhES3)后进行培养,分析其各种生物标记物和表型。

无论是在SNL饲养细胞上(A、B)还是在涂布了Matrigel的板上(C、D)进行培养,ES细胞都有成长。

培养5日后,确认到AP(碱性磷酸酶)的表达。

|
|
将hES1细胞播种至SNL饲养细胞中分别培养3、4、5、6天后进行AP染色,测量细胞集落数。使用本产品保存的细胞第3天起形成细胞集落,直至第6天细胞集落逐渐变大。使用DAP213保存的细胞在第2天仍然很少,虽然第3天的细胞集落数与使用本产品保存的细胞的细胞集落数相同,但本产品的细胞集落更大。

将使用本产品冷冻的ES细胞解冻后,通过流式细胞术分析干细胞标记TRA-1-60的表达。

使用本产品保存的细胞与DAP213的Nanog表达水平几乎相同。
图中紫色部分为Nanog阳性细胞,绿色部分为对照细胞。
本产品保存量的97.6%,DAP213保存量的96.2%为阳性。

确认了使用本产品保存的细胞的细胞核类型(染色体类型)是否有变化。

通过RT-PCR分析各mRNA表达量时采用⊿⊿Ct法。结果显示,当SOX2设置为1时,除了Nanog以外,本产品与DAP213在显示hEs细胞的未分化能的转录因子和粘附因子的表达率相同。
◆应用实例3
人iPS细胞冻融过程中StemCell Keep和DAP213的对比研究(数据提供:山梨大学)
冷冻人iPS细胞时,建议使用DAP213的简易玻璃化法。但是这个方法有着以下的问题:
● DAP213中含有的DMSO会抑制Oct3/4的表达。
● 乙酰胺具有致癌性
● DAP213可作为冷冻胚时的少量冷冻剂使用,但不适用于大容量的细胞保存。
● 添加DAP213后必须在15 s内浸没到液氮中,需要娴熟的技术。
关于人iPS细胞(201B7株,理研BRC)1,在添加StemCell Keep以及DAP213后,分别在15、45、90 s后浸没到液氮中,并保存6天。解冻后,再培养6天,在此期间测量细胞的细胞集落密度、细胞集落大小、细胞集落面积率。
细胞集落密度
使用StemCell Keep冷冻的hiPS细胞的细胞集落密度与添加DAP213 15 s后进行冷冻处理的结果相同。使用DAP213冷冻的hiPS细胞的细胞集落形成明显受浸没前的时间长短影响,但使用StemCell Keep的细胞在解冻后的细胞集落形成几乎不受影响(图1、2)。
细胞集落大小
图3、4为细胞集落大小。使用DAP213冷冻时的细胞集落比使用StemCell Keep冷冻时的细胞集落要小一些。高粘性的StemCell Keep抑制了移液时引起的水势,结果表明,StemCell Keep的细胞集落与DAP213相比更稳定。
细胞集落面积率
由于hiPS细胞的细胞集落为单层的均一结构,因此细胞集落面积大小可直接反映细胞数。使用StemCell Keep冷冻的hiPS细胞的细胞集落占有面积率与添加DAP213 15 s后进行冷冻处理的结果相同。(图5、6)。其中,即使在添加StemCell Keep45 s以及90 s后进行冷冻处理也几乎没有偏差,解冻后可稳定地恢复。
由于使用DAP213时,从添加到冷冻处理之间的时限很短,因此需要操作者娴熟的技术。但是,使用StemCell Keep的话这些问题都能迎刃而解。因此,本次对比研究中,45 s的冷冻确保了充足的时间,并且证实了hiPS细胞解冻后可以充分恢复。另外,即使操作花费了90 s,稳定性虽然会下降但也可以充分恢复,可以尽可能地回避操作过程中发生始料不及的事故的风险。
但StemCell Keep也有着试剂粘性过高,难以提取以及混合等问题。在混合时,可以多花些时间,务必仔细彻底地混合5次左右。
※使用DAP213时,hiPS细胞的存活率约为20%。
参考文献
1.Takahashi, K., et al., Cell, 131 (5), 861~872 (2007).

图1:hiPS细胞细胞集落的密度
图为每平方厘米左右的细胞集落数。

图2:解冻后第6天的细胞集落密度(相对值)
图为解冻后第6天hiPS细胞的细胞集落密度的相对值。显示了添加DAP213 15 s后进行冷冻处理的hiPS细胞的细胞集落密度为1时的各细胞集落密度。

图3:hiPS细胞细胞集落的大小
图为培养中形成的细胞集落大小。

图4:解冻后第6天的细胞集落大小(相对值)
图为解冻后第6天hiPS细胞细胞集落大小的相对值。设添加DAP213 15 s后进行冷冻处理的hiPS细胞的大小为1作为相对值。

图5:hiPS细胞细胞集落的面积占有率
图为细胞集落面积相对于培养面积的比例。

图6:解冻后第6天的细胞集落面积(相对值)
图为解冻后第6天hiPS细胞细胞集落面积的相对值。设添加DAP21315 s后进行冷冻处理的hiPS细胞的面积为1作为相对值。

图7:培养第6天的培养状态
图为培养第6天的hiPS细胞细胞集落的情况(40倍)。
◆操作步骤视频
◆细胞解冻步骤视频
◆操作方法概要
※请事先对目标细胞进行初步检测。
※为获得高存活率,当细胞悬浮于保存液后,需要立刻将vial浸没到液氮中。请提前做好充分准备再开始操作。另外,解冻时,请将预先将加热的培养基添加到vial中,迅速溶解更能提高细胞存活率。
冷冻
1. 在生物安全柜上准备好液氮。
2. 使用剥离液(0.25%胰蛋白酶 / 1 mg/mL胶原酶IV / PBS溶液)使灵长类ES/iPS细胞以细胞集落的形态剥离。
3. 离心2.中回收的细胞,去除培养基。若要冷冻多个时,请提前冷却,逐个进行以下操作。
4. 添加200 μL本产品,仔细移液,盖上盖子后尽快(约1 min内)将vial整个浸没在液氮中。
5. 储存在液氮罐或-130°C的深冷柜中。
2. 使用剥离液(0.25%胰蛋白酶 / 1 mg/mL胶原酶IV / PBS溶液)使灵长类ES/iPS细胞以细胞集落的形态剥离。
3. 离心2.中回收的细胞,去除培养基。若要冷冻多个时,请提前冷却,逐个进行以下操作。
4. 添加200 μL本产品,仔细移液,盖上盖子后尽快(约1 min内)将vial整个浸没在液氮中。
5. 储存在液氮罐或-130°C的深冷柜中。
※当在60 mm的培养皿中合流时,则可冷冻1~5 vial左右。
※液体呈透明状表明玻璃化良好。

右:正常玻璃化的案例
左:出现重结晶与浑浊的案例
解冻
1. 准备加热至37°C的培养基,以及相应数量的加入了9 mL培养基的离心管。
2. 将使用本产品冷冻的细胞的冻存管放入杜瓦瓶等盛有液氮的容器中移至生物安全柜。
3. 将取出的冻存管的盖子打开,迅速加入1 mL提前加热的培养基,移液并溶解。
4. 将3.中的全部溶液转移到1.中准备的加入了9 mL培养基的离心管中,离心并清洗。
5. 播种至饲养细胞上进行培养。
2. 将使用本产品冷冻的细胞的冻存管放入杜瓦瓶等盛有液氮的容器中移至生物安全柜。
3. 将取出的冻存管的盖子打开,迅速加入1 mL提前加热的培养基,移液并溶解。
4. 将3.中的全部溶液转移到1.中准备的加入了9 mL培养基的离心管中,离心并清洗。
5. 播种至饲养细胞上进行培养。
※解冻时请逐个解冻。
◆提供试用装!
本产品提供小包装试用装。有意者请在专用申请表中填写必要信息,提交给当地经销商。
/
| 产品编号 | 产品名称 | 产品规格 |
| VPL-A1 | StemCell Keep 无DMSO 干细胞冻存液 |
20 ml |


















